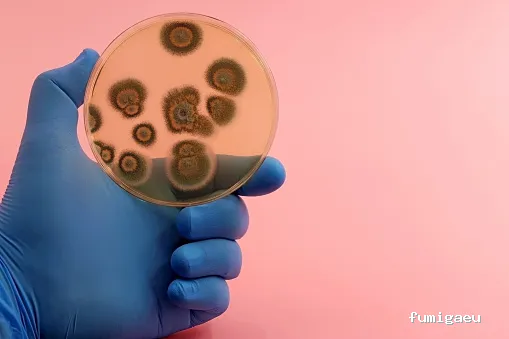
Control de Plagas Cordoba

Control de Plagas Cordoba
Empresa de fumigación y control de plagas • Córdoba
info Acerca de
Abecor es una empresa de control de plagas en Córdoba con más de 20 años de historia profesional en el ámbito de la Sanidad Ambiental, al servicio de empresas y particulares. Ofrecemos soluciones personalizadas y eficaces que garantizan y certifican los servicios realizados. Ofrecemos una amplia gama de servicios y soluciones integrales para el control de plagas en Córdoba, específicos para cada necesidad, basados en estudios previos de identificación, según norma UNE: 17210:2008 “Buenas prácticas en los planes de Desinfección, Desinsectación y Desratización”
location_on Av. Ronda de los Tejares, 11, Centro, 14001 Córdoba, España
handyman Servicios
Se identifica como de propietarias mujeres
Información proporcionada por la empresa
Amigable con la comunidad LGBTQ+
Clientela
Espacio seguro para personas transgénero
Clientela
Aparcamiento en la calle gratuito
Aparcamiento
Aparcamiento gratuito
Aparcamiento
Con aparcamiento propio
Aparcamiento
photo_library Galería de Imágenes
Resumen de las opiniones
verified Basado en reseñas reales, resumido con IA
Un aspecto destacado de este negocio es la competencia y profesionalismo de su equipo. Los clientes destacan que los técnicos saben lo que hacen y se nota que son buenos en su trabajo. Esto sugiere que el negocio invierte en la capacitación y el desarrollo de sus empleados para garantizar que brinden servicios de alta calidad. La capacidad del negocio para resolver problemas de plagas de manera efectiva y eficiente es otro factor clave que contribuye a la satisfacción de los clientes.
En general, la experiencia de los clientes con Control de Plagas Cordoba es muy satisfactoria. Aunque solo se dispone de una reseña, es evidente que el negocio se esfuerza por brindar un servicio rápido, eficiente y profesional. No hay comentarios negativos que sugieran debilidades o áreas de mejora, lo que sugiere que el negocio está cumpliendo con las expectativas de sus clientes. En resumen, la experiencia de los clientes con Control de Plagas Cordoba es muy positiva y sugiere que el negocio es una opción confiable para aquellos que necesitan servicios de control de plagas en la región de Cordoba.
star Reseñas de Clientes
Basado en 1 reseñas
Carmen Martínez
Hace 9 meses
Tuve un problemilla en casa con alguna plaga y en tiempo récord los tenía en casa trabajando a tope. Sin duda, se nota que son buenos en su trabajo y saben lo que hacen
rate_review Deja tu Reseña
Ubicación
Aviso importante
La información mostrada en esta ficha ha sido recopilada de fuentes públicas proporcionadas por el propio negocio. Esta ficha debe servir únicamente como toma de contacto inicial. Recomendamos realizar una investigación más exhaustiva y solicitar referencias antes de contratar cualquier servicio.